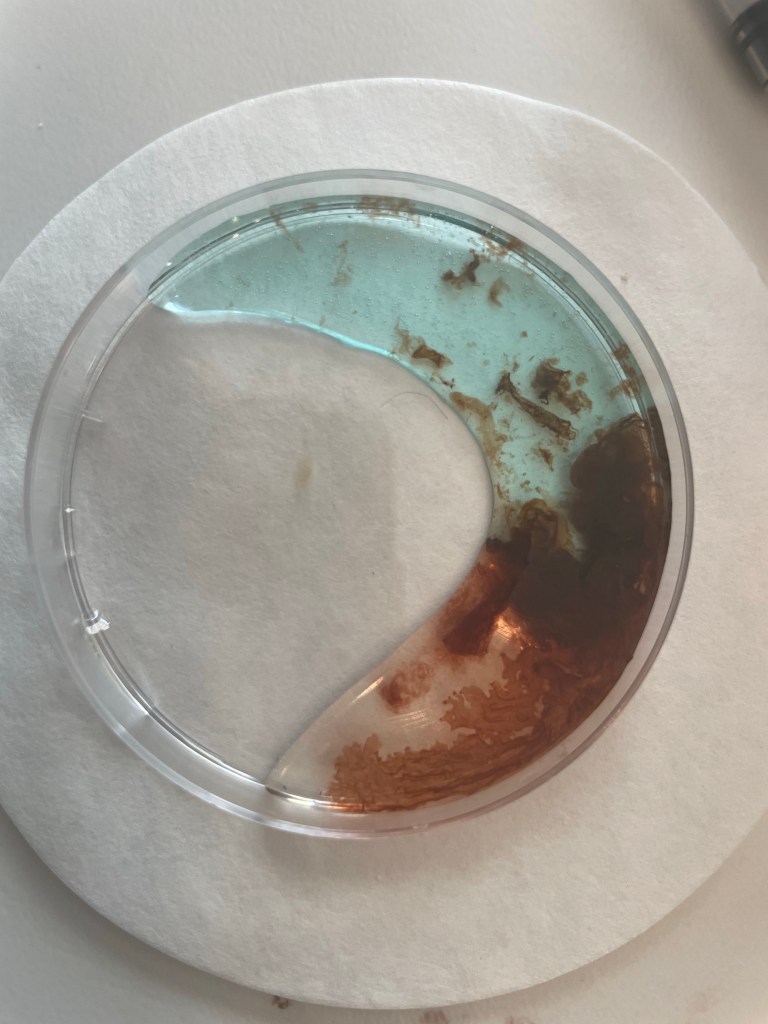

- In Morning Meeting, Start Homer Price and the tale of the Super Dooper.
- Review time-tables, Start TGTB Math Level 4; Lesson #42 Multiples and Factors, Lesson #46 Fahrenheit and Celsius, #47 Long Division Part II and Lesson #48 Adding and Subtracting Fractions.
- Multiplication review TBTB musical multiplication; Set A+B+C and Start D.
- Funexpected Math-Ongoing App
- 2 (1/2 hour) of Minecraft.
- All About Reading Level 4; Lesson#41 Read Cowboy Star and Lesson #42 -ICE, INE, ITE, IVE, ILE and Lesson #43. Activities and Fluency Sheets.
- IEW Fix-it Grammar, Pages 89-95.
- Writing, Logic links and Storyboarding with Linda Jordon, Fridays.
- In Writing Explode the Code-Writing Level #6 Pages 100-109.
- Story of the World: Chapter 21 Fighting over North America; Three Pointless Wars.
- Weekly Group Movement Class-Together in Movement
- Snake Discovery.
- Seneca Creek State Park
- Read Aloud; Detectives in Togas.
- Read Alone: FNAF fiction + Procession of Cats.
- Mark Roper Elephant Toothpaste and Liquid Sand. MEL Science Ocean Science
- Final Week of the Dragon Sculpture
- Thriftstore Guitar Makeover